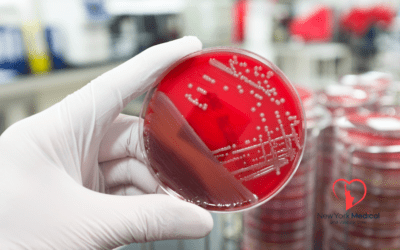
Public Health Initiatives Addressing Emerging Diseases

Blog Articles
Medical blog of New York Medical and Vascular Care: Trusted health insights for our patients
Understanding the Bird Flu Outbreak: What You Need to Know in 2025
Bird flu, or avian influenza, has resurfaced as a global health concern in 2025. With increasing cases reported in both animals and humans, understanding the risks and taking preventive measures is...
Bird Flu, Measles, and Polio: Are We Prepared for the 2025 Resurgence?
The year 2025 has brought renewed concerns about infectious diseases once thought to be under control. With the resurgence of bird flu, measles, and polio, healthcare professionals and patients...
Understanding Chlamydia: Symptoms, Prevention, and Treatment
Chlamydia is one of the most common sexually transmitted infections (STIs) worldwide, affecting millions of people each year. Often called a “silent” infection, it frequently presents no symptoms,...
Prostate Cancer: Understanding Symptoms, Prevention, and Treatment
Prostate cancer is one of the most common cancers among men, especially those over 50. Early detection plays a crucial role in successful treatment, making it essential for men to understand the...
Understanding Pneumonia: Symptoms, Prevention, and Treatment
Pneumonia is a serious infection that inflames the air sacs in one or both lungs, causing them to fill with fluid or pus. It can range from mild to life-threatening, affecting people of all ages but...
Understanding Bronchitis: Prevention, Symptoms, and Treatments
Bronchitis is a common respiratory condition that affects millions of people each year. It occurs when the bronchial tubes, which carry air to your lungs, become inflamed, leading to coughing and...
Public Health Initiatives Addressing Emerging Diseases
Emerging diseases pose a significant challenge to global health systems, often arising unexpectedly and spreading rapidly. From new infectious agents to re-emerging threats, public health...
Focus on Mental Health and Wellness: A Growing Priority in Healthcare
Mental health and wellness are increasingly recognized as essential components of overall health, shaping how we think, feel, and interact with the world. The stigma surrounding mental health is...
Advancements in Gene Therapy: Transforming the Future of Medicine
Gene therapy is revolutionizing the way we treat and potentially cure genetic disorders and other diseases. This cutting-edge medical innovation focuses on modifying or replacing faulty genes to...
Peripheral Angiograms and Peripheral Artery Disease (PAD)
Peripheral artery disease (PAD) is a common vascular condition affecting millions of people worldwide. It occurs when blood flow to the extremities, typically the legs, is reduced due to narrowed or...